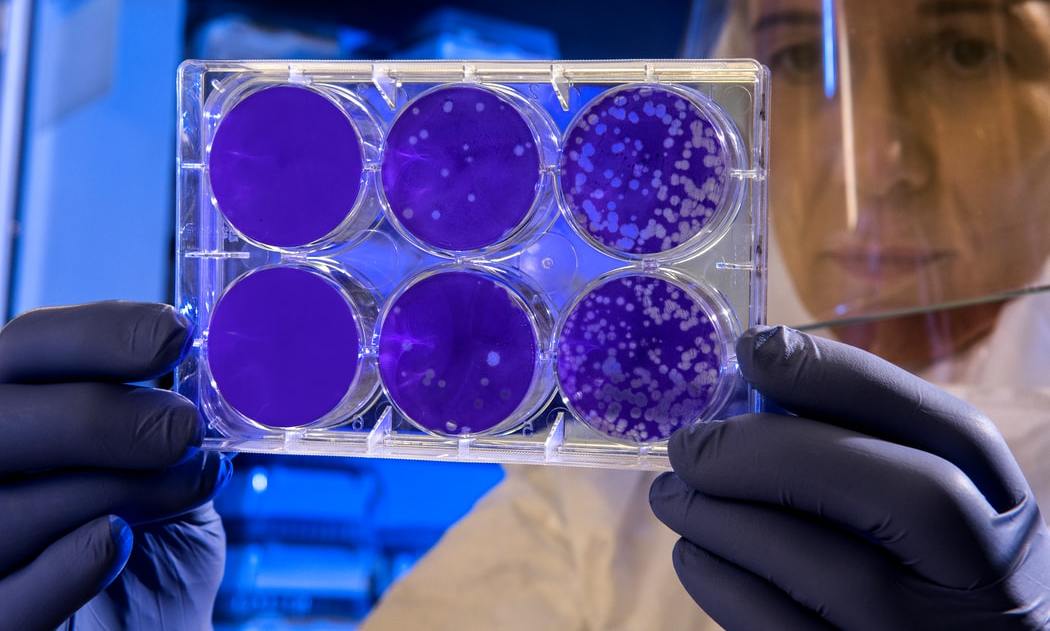

Las bacterias podrían ser la clave para la curación del coronavirus
Investigadores del Instituto Weizmann comparan su descubrimiento al de los antibióticos, señalando que podría ser la clave para la creación de medicamentos que curen varios virus, tal vez también el coronavius
Las bacterias se protegen de los virus atacándolas y nos pueden enseñar como batir al coronavirus. Crédito: Rotem Sorek, Weizmann Institute | Cortesía
Las bacterias podrían ser la clave para la curación del Covid-19 según el equipo del Instituto de Ciencia Weizmann de Israel que ha identificado las moléculas que las bacterias producen para protegerse cuando están siendo atacadas por virus.
La investigación publicada en la revista científica Nature indica que las moléculas, que también pueden ser creadas artificialmente, tienen la misma capacidad de luchar contra virus si son introducidas en células humanas infectadas. Por ello están poniendo a prueba la teoría en tejido humano.
Un laboratorio israelí, Pantheon Biosciences, ha comprado ya los derechos para desarrollar una medicación antiviral a partir de este descubrimiento.
El jefe de la investigación aseguró que este descubrimiento podría ayudar a crear tratamientos que curen diferentes virus. “Y tal vez ofrecer una solución para la próxima pandemia o, incluso, para ésta”, dijo Rotem Sorek, del departamento de Genética molecular de Weizmann.
El paralelismo que encuentra entre este descubrimiento y el de los antibióticos es que en las bacterias y los hongos se encuentran compuestos que son capaces de matar o frenar infecciones bacterianas.
En los últimos años se ha demostrado, por Sorek y otros investigadores, que las bacterias tienen sistemas inmunes muy sofisticados a pesar de su tamaño microscópico. Además, el equipo de Sorek ha descubierto que la viperina, una enzima del sistema inmune de los mamíferos, es también parte del sistema inmune de las bacterias.
“A mucha gente le sorprende que los virus ataquen a las bacterias y que las bacterias tengan sus propios sistemas de defensa”, explicó el especialista. “Y hemos descubierto que una de las maneras en las que las bacterias se defienden contra los virus es haciendo que su viperina produzca componentes antivirales, que son pequeñas moléculas que impiden que el virus se multiplique dentro de la bacteria”, agregó.
El equipo señaló que el mecanismo que impide que el virus se replique podría también impedir la reproducción de los virus que afectan a los humanos.
“Es algo que aún no está comprobado, pero lo estamos testando en estos momentos”, señaló Sorek.
Los investigadores descubrieron los componentes en un amplio proyecto en el que analizaron las secuencias genéticas de unas 100 mil bacterias y comprobaron que cientos de ellas generaban la viperina.
Sorek señaló que el descubrimiento es emocionante porque descubrió una familia de moléculas y eso es lo que le lleva a pensar que las diferentes moléculas podrán ser usadas para luchar contra diferentes tipos de virus.





